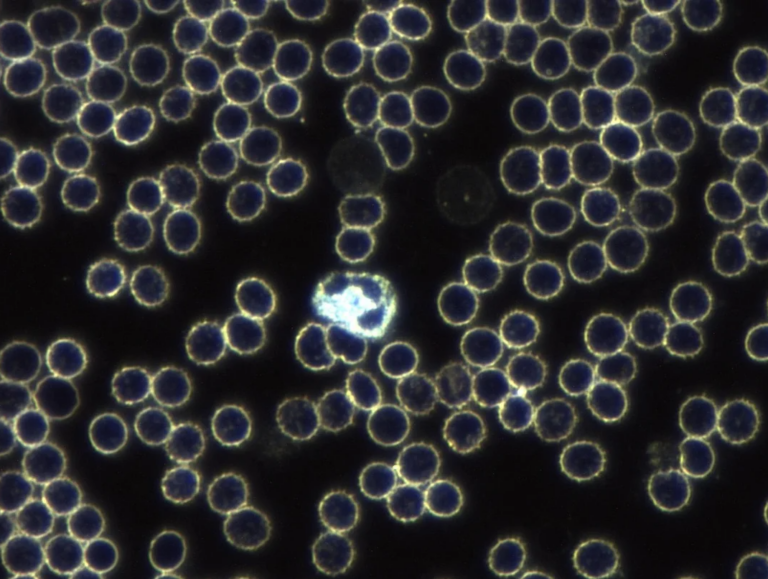

Vyšetření
Vyšetření z kapky krve v temném poli mikroskopu neboli darkfield diagnostika je soustavné pozorování čerstvě odebrané kapky, které poskytuje vizualizaci všech elementů krve. Vyšetření včas upozorní na raná stádia onemocnění, akutních infekcí, alergií, nedostatečné trávení bílkovin, záněty, přítomnost bakterií či plísní.
Co je vyšetření z kapky krve?
Živá kapka krve umí také ukázat na nevhodné stravovací návyky či na nedostatečný metabolismus vitamínů, minerálů a stopových prvků v těle. Nese informaci o našem imunitním systému a pomůže odhalit pravou příčinu již vzniklých chorob. Vyšetření z kapky krve je metoda, která také slouží jako prevence. Na základě získaných informací můžeme doporučit vhodnou výživu organismu a další postupy pro předcházení veškerým civilizačním onemocněním.
Co je cílem vyšetření?
Cílem je prostřednictvím videoprojekce zorného pole mikroskopu vysvětlit kvalitu a stav krevních složek (červené krvinky, bílé krvinky, krevní destičky, plazma). Na základě zjištění pak umíme poradit se správnou výživou, doporučit vhodné výživové doplňky na zlepšení nevyváženého stavu organismu, a tím přirozeně navrátit zdraví a pohodu organismu. Vyšetření také dokáže varovat před náhlými cévními příhodami, poškozením jaterní tkáně a degenerativními onemocněními. Při stávajících problémech může pomoci objasnit příčinu, a tím pádem stanovit nejvhodnější řešení.

Vyšetření v současné době provádíme pouze na pobočce v Brně.
Co lze vyšetřením zjistit?
- Funkčnost imunitního systému
- Překyselení organismu
- Stravovací návyky
- Chronické a akutní záněty
- Potřebu detoxikace organismu, přítomnost toxinů v těle
- Využití kyslíku a jeho schopnost zásobovat orgány a tkáně
- Sklony k degenerativním onemocněním (ateroskleróza, roztroušená skleróza, Parkinsonova nemoc aj.)
- Stav červených a bílých krvinek
- Přítomnost bakterií, virů, plísní a kvasinek
- Přítomnost těžkých kovů, krystalů cholesterolu a urátů, plaků
- Hromadění kyseliny močové, riziko dny
- Nedostatečné množství vitamínů, kyseliny listové, železa
- Srážlivost krve
- Sníženou obranyschopnost
- Parazitická onemocnění
- Stav proteinů – kvalita jejich trávení
- Patogenní mikroorganismy a jejich vývoj
- Riziko infarktu a mozkové mrtvice
Co vyšetřením nelze zjistit?
- Glykemický stav krve
- Přesnou hodnotu pH krve
- Krevní skupinu
- Těhotenství
- Genetické predispozice (dědičné vady a poruchy)
- Metabolický typ
Jak vyšetření z kapky krve probíhá?
- Vyplníte vstupní dotazník a darkfield specialista s vámi udělá úvodní rozhovor.
- Specialista vydezinfikuje prst na vaší ruce, kterou nepíšete.
- Jednorázovou jehličkou provede vpich a odebere se kapka krve přímo na sklíčko, následuje pozorování krve pod mikroskopem.
- Samotná konzultace a interpretace výsledků klientovi trvá 30–60 minut.
Vyšetření z kapky krve je neinvazivní a bezbolestné.
Před samotným vyšetřením je důležité dodržovat několik pravidel:
- 24 h před odběrem jíst lehkou racionální stravu (vynechte potraviny s vysokým obsahem tuků a cukrů)
- 24 h před odběrem nepít alkohol
- Minimálně 6 hodin před odběrem nejíst (nejlepší je objednat se na ranní termín a přijít nalačno)
- Před vyšetřením vypít 1–1,5 l čisté nesycené a neslazené vody (pít průběžně v rozmezí několika hodin, není dobré vypít doporučovaný obsah těsně před odběrem)
- 6 hodin před odběrem nepít kávu, černý a zelený čaj, mléko
- 10 minut před vyšetřením si již nemýt ruce a nemnout prsty
U žen se vyšetření nedoporučuje absolvovat v době menstruace.
Cena vstupního vyšetření je 2 000 Kč, každý další kontrolní odběr stojí 1 500 Kč.